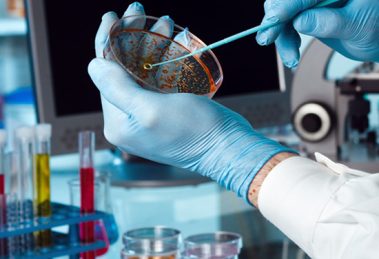

A Empresa Brasileira de Pesquisa e Inovação Industrial (EMBRAPII) está presente...
EMBRAPII discute o potencial de inovação de startups na área de biotecnologia

A Empresa Brasileira de Pesquisa e Inovação Industrial (EMBRAPII) está presente...